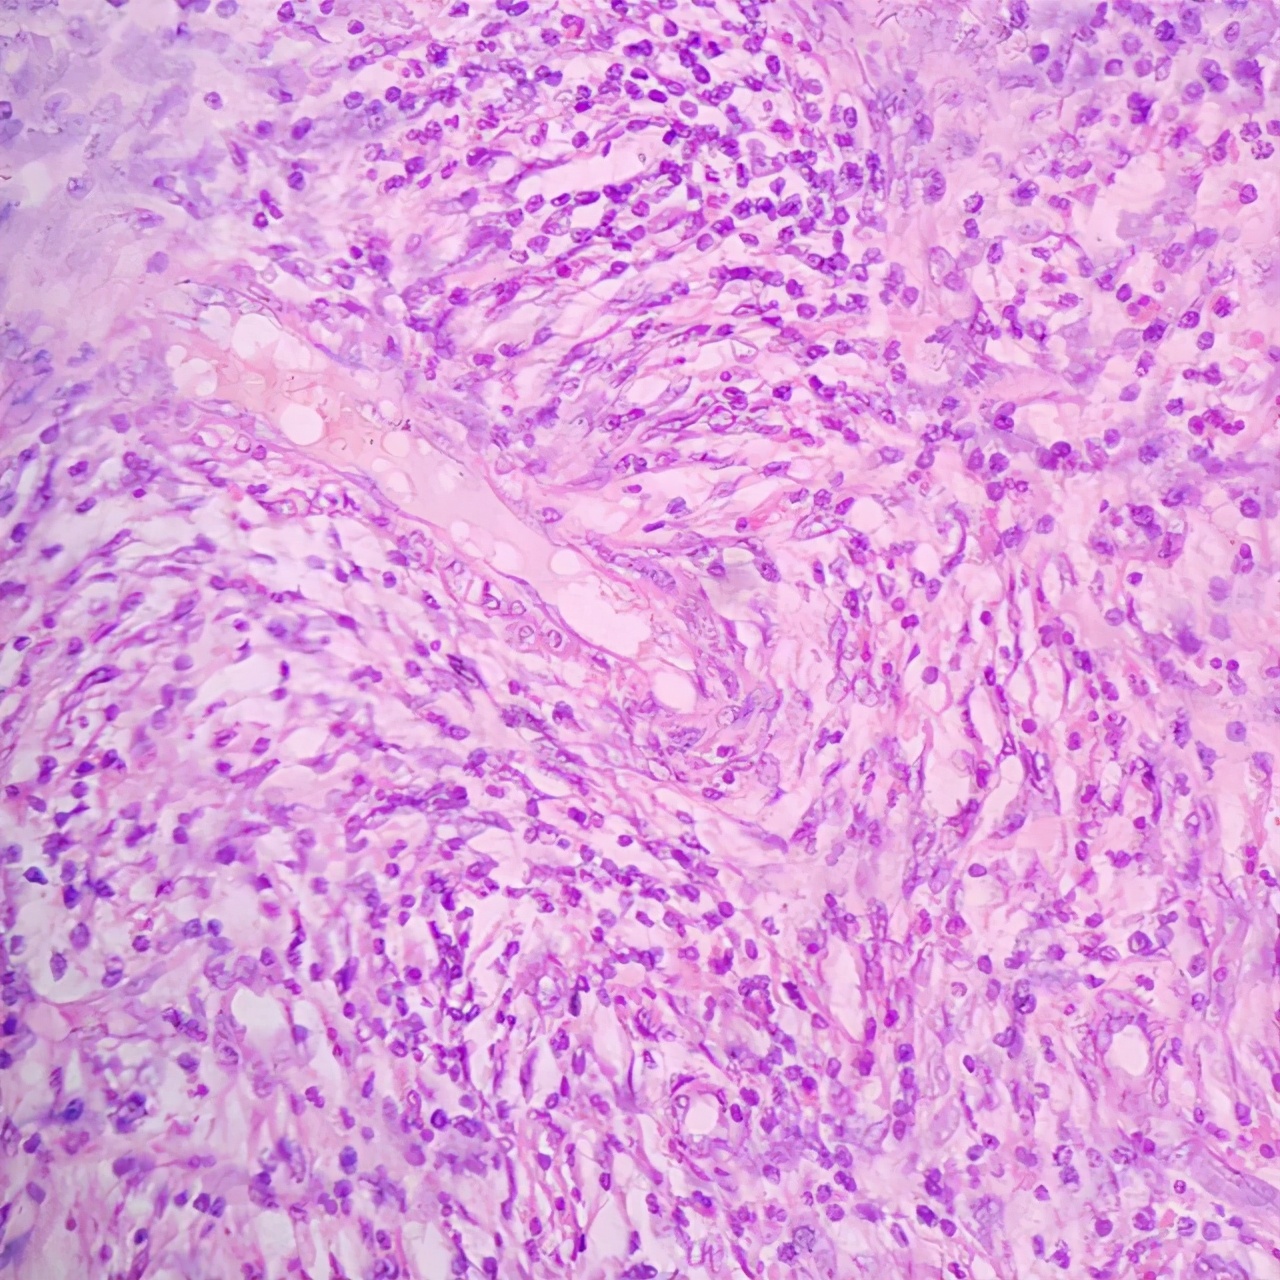
所有的肠癌都是由肠息肉演变的吗,所有肠癌都是肠息肉发展来的吗

杨先生今年38岁,是一名公职人员,杨先生在事业上没有太大的追求,但是喜欢尝试各种美食,空余的时间也是用来琢磨佳肴,但是近来一段时间,杨先生总是拉肚子,大便看着好像黏糊糊的,甚至有几次表面覆着少量血液,这让杨先生慌了神。
“医生,我最近时常拉肚子,大便的形状也瞧着很不正常,颜色比较黑,有时可看到血液,不过我没有感觉到痛,我是得了什么病吗?”
在和杨先生的对话中,我了解到他的基本作息习惯,以及家族中有几位长辈和父亲均患过息肉病。
“杨先生,根据我从您这获取的信息,您平日里的用食富含蛋白及脂肪,且运动量不佳,加上您有家族息肉史和您所描述的症状,初步判断您是肠息肉。但是为了确诊,我会对您进行直肠指诊,以及开出一些相关检查。”
杨先生拿到内镜等检查报告后回到我这。
“杨先生,刚才我在指诊时触碰到一个光滑隆状突起,您的肠镜报告显示有两个息肉,可以确诊您有肠息肉。”

肠息肉是指肠道粘膜表面的异常增生凸起, 可生长在肠道的任何位置,以直肠和乙状结肠最常见,形状各异,可单发,可多发,也可呈块状分布。 息肉的病理性质不同,癌变可能性也相异。 其病发率与年纪增长成一定正比关系,男性的易患性高于女性。
根据息肉的癌变性可分为两大类型:
1. 腺瘤型息肉。此型最常见, 粘膜上皮出现异型增生,组织细胞学特点为细胞核增大形变,颜色变深,其下又有:
·管状。所占比例最高,属于良性肿瘤 ,癌变可能型在三者中最低,病情进展缓慢,但还是需要定期检查外界因素或其自身恶变。
·绒毛状。 此病理性息肉的 癌变率最高 ,如患者没有进行手术治疗,则癌变可能性高达50%,属于一种癌前病变疾病。

·混合型。 是管状和绒毛状的混合型,癌变概率也处于两者之间。
2. 非腺瘤型息肉。 这一类息肉较少发生癌变,息肉多呈圆形,表面光滑。
·幼年型。幼儿病发率相对高 。直径在10mm左右,质软,色深红,一般有蒂,或为错构瘤(不是肿瘤,临床上认为是正常组织结构的错误组合、排列),或为炎症迁延所致的粘液积聚。可通过指诊、肠镜发现。
·增生型。是非腺瘤型息肉中最多见的病理型, 息肉细胞分裂,分化度低,粘膜可见增厚,直径小,数量多,通常患者不会感到明显不适,需要经过组织学、肠镜检查发现。
·炎性。 数多无蒂, 主要是其他疾病引起(克罗恩疾病、阿米巴痢疾等),炎症长时间刺激肠道,成纤维细胞发生增殖,故实质是肉芽组织, 与正常息肉不同,临床症状也是以原发疾病为主。通过内镜、病理组织检查诊断,可见息肉有糜烂肿胀等炎症表现。
息肉病: 是指 肠道息肉的生长分布超过百数 ,并有相应症状。
肠息肉具体病理性质不尽相同,形成原因也不一样, 主要的病因有:
基因与遗传 。在大肠息肉的患者中,约十分之一有家族息肉病史的背景 ,如家族性腺瘤性息肉病 (FAP)是外显率达100%的常染色体显性遗传病, 其发生与位于5号染色体上的APC基因突变密切相关 ,后者已被证实可通过调节CRT实现抑制肿瘤的功能。

慢性炎症、大便的长期作用。 已知炎症是机体与致炎因子的博弈过程,后者会破坏正常组织细胞,机体收到反馈会分泌免疫细胞进行消除,同时会有炎性物质产生,表现出来就是典型的红肿热痛反应, 健康细胞损伤坏死会刺激大量新的细胞生成,一方面繁殖速度过快可增加基因突变的几率,一方面促进异型组织生成, 即息肉出现可能性升高,如溃疡性结肠炎等肠道炎症。同理大便的残渣留存在直肠也会一直刺激肠粘膜异变。
其他可诱发息肉的因素:
①年纪。 人体的机能伴随年纪的增大而衰退,与疾病斗争的能力也逐渐减弱,肠息肉的病发率高于年轻人。
②不良生活习惯。既包含饮食方面,也包括作息方面, 长 期食入蛋白、脂肪、糖等含量高的食物,加重了肠道的消化负荷,也极易造成机体的脂代谢、糖代谢等生理过程紊乱 ,肠道发生异常增生的概率升高;无节制的吸烟饮酒对身体的伤害已经被众多临床研究证实,其中的有害物质、致癌物质可诱导相应的抑癌基因改变,丧失原有功能。

肠息肉初期因为息肉体积小,或者数量少,故一般无显著异常表现,但随着息肉变大变多, 常见的临床症状有:
(1)便血。 息肉在大肠高发,所以排便时经粪便的摩擦可能会引起息肉出血, 沾染在大便表面,量少居多 ,少数急性症状的患者会大出血。
(2)排便习惯改变。多发生于息肉体积较大的情形 ,特别是直肠的息肉可刺激肠粘膜产生频繁便意;由慢性炎症所致的肠息肉腹泻情况常见;绒毛型腺瘤息肉便中可有黏液。
除上述两种症状外 ,可继发出现贫血、腹胀、腹痛、恶心等症状。
患者通常因为便血选择就医,询问基本的病史后, 还需做下列检查来确诊此病:

指诊。 可快捷发现直肠部分的息肉,可了解息肉的质地、光滑度等信息。
肠镜 。此方法可更清晰地掌握息肉的数量、大小、生长部位等情况,并且可以帮助切割部分组织进行病理检查。
粪便隐血试验。
钡剂灌肠。 将钡剂稀释后注入肛门内,再注入气体,借助影像工具观察肠道的各种病变。
多发性息肉癌率很高,故通常借用手术进行切除,且息肉存在不小的复发可能性,术后需定期到医院检查, 有炎症的病人应服用抗炎药物配合治疗;同时患者生活中要改正不良习惯,饮食尽量清淡,作息规律。
参考文献:
[1]于潜,孙仰白.家族性腺瘤性息肉病与APC基因相关性研究进展[J].中国现代医药杂志,2008(03):130-132.